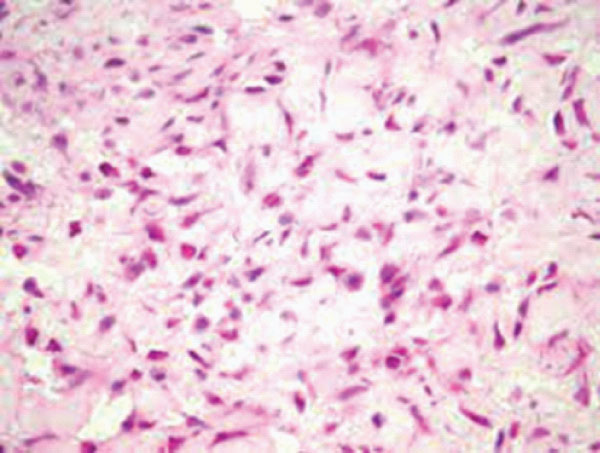

Nodular fasciitis emerges as a benign, self limited, mesenchymal neoplasm of fibroblastic or myofibroblastic derivation. The morphologically distinctive neoplasm can be appropriately classified with cogent histological examination. Upon immunohistochemistry, nodular fasciitis demonstrates a myofibroblastic immune phenotype. Chromosomal rearrangements within USP6 gene are characteristic. Additionally designated as cranial fasciitis, nodular fasciitis enunciates significant anatomic distribution of lesions. Terminology of pseudo–sarcomatous fasciitis remains obsolete [1,2].
Frequently encountered, the mesenchymal neoplasm is predominantly discerned in young adults although no age of tumour emergence is exempt. A specific gender predilection is absent [1,2].
Nodular fasciitis commonly emerges within upper or lower extremities, head and neck or trunk although no site of tumour emergence is exempt. Exceptionally, tumefaction may be discerned as an intravascular, intraarticular, intra–parotid or cranial lesion or incriminates placenta. Nodular fasciitis is frequently confined to subcutaneous region although lesions may originate within dermis, fascia or skeletal muscle.
Of obscure aetiology, nodular fasciitis may arise as a sporadic neoplasm [1,2]. Neoplastic cells preponderantly depict genomic fusion of MYH9–USP6 genes. In addition, several genes may collaborate with USP6 gene. Genetic rearrangement of USP6 gene can be ascertained with molecular techniques as fluorescent in situ hybridization (FISH), polymerase chain reaction (PCR) or next generation sequencing (NGS) [1,2].
Tumefaction may be asymptomatic or manifests as a tender, mildly painful, miniature nodule generally < 3 centimetre magnitude. Enlarged or rapidly progressive lesions necessitate demarcation from various malignant neoplasms [1,2]. Upon gross examination, a solitary, soft to firm, greyish/ white, tan or light pink tumefaction is discerned. Tumour perimeter may be circumscribed or infiltrative. Characteristically, tumour magnitude is <3 centimetres. Exceptionally, neoplasms of up to 7 centimetre diameter may be delineated. Cut surface is fibrotic, glistening and well circumscribed [1,2].
Upon microscopy, the variably cellular tumefaction enunciates a myxoid to collagenous extracellular matrix with foci of cystic degeneration. Ancient lesions are preponderantly collagenous [1,2]. Tumefaction is comprised of spindle–shaped or stellate cells imbued with indistinct cytoplasm and bland, elliptical nuclei. Neoplastic cells configure a loose, fascicular or storiform pattern, designated as ‘tissue culture–like’ or ‘feathery’ growth pattern. Mitotic activity is significant although atypical mitotic figures are absent. Red cell extravasation is frequent [1,2]. Tumour parenchyma is intermingled with an inflammatory exudate composed of disseminated lymphocytes, histiocytes or osteoclast–like giant cells [1,2]. Upon ultrastructural examination, characteristic features of fibroblasts, peripheral, longitudinal myofilaments and hemidesmosome–like structures can be discerned [1,2].
Nodular fasciitis is immune reactive to smooth muscle actin (SMA), muscle specific actin (MSA) or calponin [3,4]. Nodular fasciitis is immune non–reactive to desmin, h–caldesmon, S100 protein, SRY– related HMG–box 10(SOX10), CD34, ETS family transcription factor (ERG), epithelial membrane antigen (EMA) or keratin [3,4] (Figure 1 & 2).
Nodular fasciitis requires segregation from neoplasms such as dermatofibrosarcoma protuberans, desmoid type fibromatosis or fibrous histiocytoma [3,4]. Upon plain radiography or magnetic resonance imaging, demarcation of nodular fasciitis from diverse sarcomas can be challenging [3,4]. Simple surgical extermination of neoplasm is optimal and recommended therapeutic technique. Occasionally, spontaneous tumour regression may occur following cogent tissue sampling [3,4]. Following inadequate surgical eradication, tumour reoccurrence is exceptional [3,4].

Figure 1: Nodular fasciitis demonstrating fascicles of spindles–shaped cells with uniform, ovoid nuclei and circumscribing fibrotic stroma with minimal mitosis [5].
Figure 2: Nodular fasciitis delineating bundles of stellate and spindle–shaped cells with uniform, elliptical nuclei and encompassing fibrotic stroma [6].
None.
Author declares that there is no Conflict of interest.